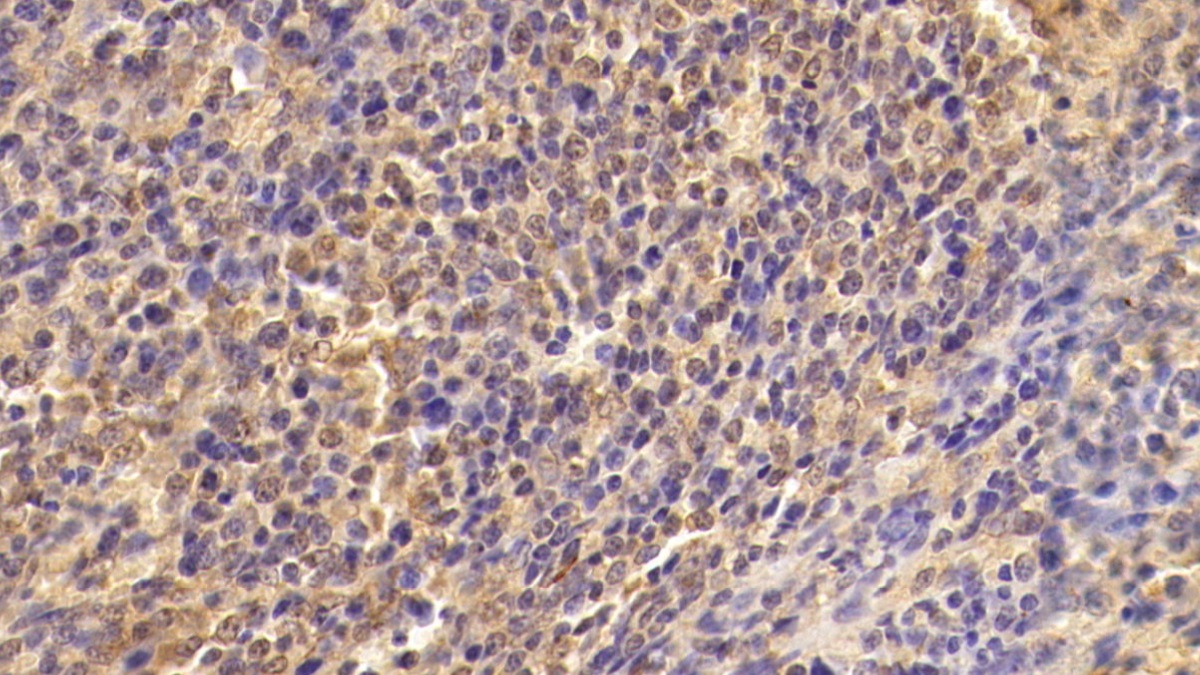

Monoclonal Antibody to Transforming Growth Factor Beta 1 (TGFb1)
TGF-B1; CED; DPD1; LAP; Camurati-Engelmann Disease; Latency-associated peptide
- Product No.MAA124Hu24
- Organism SpeciesHomo sapiens (Human) Same name, Different species.
- SourceMonoclonal antibody preparation
- HostMouse
- Potency (Clone Number)D1
- Ig Isotype IgG1 Kappa
- PurificationProtein A + Protein G affinity chromatography
- LabelNone
- Immunogen RPA124Hu02-Recombinant Transforming Growth Factor Beta 1 (TGFb1)
- Buffer Formulation0.01M PBS, pH7.4, containing 0.05% Proclin-300, 50% glycerol.
- TraitsLiquid
- Concentration1mg/ml
- Organism Species Moren/a
- ApplicationsIHC
If the antibody is used in flow cytometry, please check FCM antibodies. - DownloadInstruction Manual
- UOM 20µl100µl 200µl 1ml 10ml
- FOB
US$ 95
US$ 222
US$ 317
US$ 793
US$ 3170
For more details, please contact local distributors!
SPECIFITY
The antibody is a mouse monoclonal antibody raised against TGFb1. It has been selected for its ability to recognize TGFb1 in immunohistochemical staining and western blotting.
USAGE
Western blotting: 0.5-2µg/mL;
Immunohistochemistry: 5-20µg/mL;
Immunocytochemistry: 5-20µg/mL;
Optimal working dilutions must be determined by end user.
STORAGE
Store at 4°C for frequent use. Stored at -20°C in a manual defrost freezer for two year without detectable loss of activity. Avoid repeated freeze-thaw cycles.
STABILITY
The thermal stability is described by the loss rate. The loss rate was determined by accelerated thermal degradation test, that is, incubate the protein at 37°C for 48h, and no obvious degradation and precipitation were observed. The loss rate is less than 5% within the expiration date under appropriate storage condition.
GIVEAWAYS
INCREMENT SERVICES
-
 Antibody Labeling Customized Service
Antibody Labeling Customized Service
-
 Protein A/G Purification Column
Protein A/G Purification Column
-
 Staining Solution for Cells and Tissue
Staining Solution for Cells and Tissue
-
 Positive Control for Antibody
Positive Control for Antibody
-
 Tissue/Sections Customized Service
Tissue/Sections Customized Service
-
 Phosphorylated Antibody Customized Service
Phosphorylated Antibody Customized Service
-
 Western Blot (WB) Experiment Service
Western Blot (WB) Experiment Service
-
 Immunohistochemistry (IHC) Experiment Service
Immunohistochemistry (IHC) Experiment Service
-
 Immunocytochemistry (ICC) Experiment Service
Immunocytochemistry (ICC) Experiment Service
-
 Flow Cytometry (FCM) Experiment Service
Flow Cytometry (FCM) Experiment Service
-
 Immunoprecipitation (IP) Experiment Service
Immunoprecipitation (IP) Experiment Service
-
 Immunofluorescence (IF) Experiment Service
Immunofluorescence (IF) Experiment Service
-
 Buffer
Buffer
-
 DAB Chromogen Kit
DAB Chromogen Kit
-
 SABC Kit
SABC Kit
-
 Long-arm Biotin Labeling Kit
Long-arm Biotin Labeling Kit
-
 Real Time PCR Experimental Service
Real Time PCR Experimental Service
| Magazine | Citations |
| Cardiovascular Research | Metformin attenuates cardiac fibrosis by inhibiting the TGFβ1–Smad3 signalling pathway OxfordJournals: source |
| Immunopharmacology and Inflammation | Evidence for the complementary and synergistic effects of the three-alkaloid combination regimen containing berberine, hypaconitine and skimmianine on the ulcerative colitis rats induced by trinitrobenzene-sulfonic acid ScienceDirect: S0188440910001049 |
| Biochemical and Biophysical Research Communications | Chronic angiotensin-(1–7) administration improves vascular remodeling after angioplasty through the regulation of the TGF-β/Smad signaling pathway in rabbits ScienceDirect: S0006291X09017021 |
| European Cells and Materials | Incorporating pTGF-β1/calcium phosphate nanoparticles with fibronectin into 3-dimensional collagen/chitosan scaffolds: efficient, sustained gene delivery to stem cells for chondrogenic differentiation. Pubmed: 22314694 |
| Journal of Animal and Veterinary Advances | A Soluble Antigen-Specific Factor from CD4+CD25+ T Cells of OVA Tolerant Mice Inducing OVA-Specific Peripheral Tolerance Independently in vivo Medwell: 2011642650 |
| revue de medecine veterinaire | Increased circulating concentrations of PDGF-BB and TGF-β1 in canine generalised demodicosis Revmedvet: Source |
| Biomedical and Environmental Sciences | The Intervention Effect of Rosiglitozone in Ovarian Fibrosis of PCOS Rats Besjournal: Source |
| The Open Respiratory Medicine Journal | Biomarkers of Fibroproliferative Healing in Fibrosing Idiopathic Interstitial Pneumonias PubMed: PMC3551240 |
| PLoS ONE | A Combinatorial Relative Mass Value Evaluation of Endogenous Bioactive Proteins in Three-Dimensional Cultured Nucleus Pulposus Cells of Herniated Intervertebral Discs: Identification of Potential Target Proteins for Gene Therapeutic Approaches Plosone: Source |
| J Physiol Pharmacol. | Fibrogenic response of hepatic stellate cells in ovarectomised rats exposed to ketogenic diet Pubmed: 23568967 |
| international Journal of food and nutritional sciences | EVALUATION OF PHYSICO-CHEMICAL PROPERTIES OF COLOSTRUM SUPPLEMENTED DAHI Ijfans: Source |
| Journal of ethnopharmacology | Multitargeted protective effect of Abacopteris penangiana against carrageenan-induced chronic prostatitis in rats. Pubmed: 24211397 |
| Int J Clin Exp Pathol | Development of a KLD-12 polypeptide/TGF-β1-tissue scaffold promoting the differentiation of esenchymal stem cell into nucleus pulposus-like cells for treatment of intervertebral disc degeneration Ijcep:Source |
| Am J Physiol Regul Integr Comp Physiol. | Prolactin anterior pituitary expression and circulating levels are reduced in obese and diabetic rats: Role of TGFβ and TNFα Pubmed:25715833 |
| Exp Ther Med. | PAR2, IL4R, TGFβ and TNFα in bronchoalveolar lavage distinguishes extrinsic allergic alveolitis from sarcoidosis Pubmed:Pmc4079423 |
| International Journal of Molecular Medicine | Effect of combined treatment with rosuvastatin and protein kinase Cβ2 inhibitor on angiogenesis following myocardial infarction in diabetic rats Pubmed:25524396 |
| Indian J Pharmacol | Effect of coenzyme Q10 alone and its combination with metformin on streptozotocin-nicotinamide-induced diabetic nephropathy in rats Pubmed:25538335 |
| Prostaglandins, Leukotrienes and Essential Fatty Acids (PLEFA) | Ameliorative potential of omega 3 fatty acids and HMG-CoA reductase inhibitors on experimentally-induced non-alcoholic steatohepatitis Pubmed:25541279 |
| Anadolu Kardiyol Derg. | A novel association between TGFb1 and ADAMTS4 in coronary artery disease: A new potential mechanism in the progression of atherosclerosis and diabetes. Pubmed:25592103 |
| Journal of Drug | Targeting Apoptosis, Advanced Glycation End Products and Transforming Growth Factor-β1 by Biguanides and Resveratrol to Ameliorate Experimentally-induced Diabetic Nephropathy Pdf: Drugs |
| Mol Med Rep | NIM811 downregulates transforming growth factor PubMed: 26573209 |
| The Tohoku Journal of Experimental Medicine | Salvia Miltiorrhiza Bge.f.alba Ameliorates the Progression of Monocrotaline-Induced Pulmonary Hypertension by Protecting Endothelial Injury in Rats PubMed: 26074502 |
| Oncol Rep | Therapeutic effects of bone marrow-derived mesenchymal stem cells on radiation-induced lung injury PubMed: 26717975 |
| J Surg Res | Epigallocatechin-3-gallate reduces tubular cell apoptosis in mice with ureteral obstruction PubMed: 25913488 |
| Histol Histopathol | Estrogen-deficient osteoporosis enhances the recruitment and activity of osteoclasts by breast cancer cells PubMed: 26254457 |
| Clin Exp Pharmacol Physiol | Silymarin attenuates paraquat-induced lung injury via Nrf2-mediated pathway in vivo and in vitro PubMed: 26173462 |
| Immunologic Research | Mesenchymal stromal cell-dependent reprogramming of Kupffer cells is mediated by TNF-α and PGE6 and is crucial for liver transplant tolerance PubMed: 25982596 |
| Journal of Neuroscience | MSX3 Switches Microglia Polarization and Protects from Inflammation-Induced Demyelination PubMed: 25904788 |
| J Reprod Immunol | The immunomodulating effect of seminal plasma on T cells PubMed: 25799173 |
| Nutr Cancer | Camel Milk: Potential Utility as an Adjunctive Therapy to Peg-IFN/RBV in HCV-4 Infected Patients in Egypt PubMed: 26492130 |
| Int J Clin Exp Med | Uighur medicine abnormal savda munzip (ASMq) suppresses expression of collagen and TGF-β1 with concomitant induce Smad7 in human hypertrophic scar … PubMed: 26309506 |
| Int J Clin Exp Pathol | Development of a KLD-12 polypeptide/TGF-β1-tissue scaffold promoting the differentiation of mesenchymal stem cell into nucleus pulposus-like cells for treatment of intervertebral disc degeneration. PubMed: 25972996 |
| International Immunopharmacology | Oxymatrine attenuates CCl 4-induced hepatic fibrosis via modulation of TLR4-dependent inflammatory and TGF-β1 signaling pathways Pubmed:27179304 |
| Deletion Polymorphism and Chronic Obstructive Pulmonary Disease | ReCavia (Guinea pig )lation of Viral Infection-induced Airway Remodeling Cytokine Production by the TLR3-EGFR Signaling Pathway in Human Bronchial Epithelial Cells Pubmed:27075970 |
| Tissue and Cell | Human umbilical cord blood-mesenchymal stem cells transplantation renovates the ovarian surface epithelium in a rat model of premature ovarian failure: Possible direct and indirect effects Pubmed:27233913 |
| Cancer Medicine & Anti Cancer Drugs | Ameliorative Potential of Tamoxifen/Thymoquinone Combination in Patients with Breast Cancer: A Biochemical and Immunohistochemical Study open-access:1000102 |
| Sleep Sciences | Th17 Cell Related Cytokine Profiles in Narcolepsy and Other Types of Excessive Daytime Sleepiness article:15 |
| Tissue Cell. | Ameliorative potential of fluoxetine/raloxifene combination on experimentally induced breast cancer Pubmed:26881735 |
| International Journal of Molecular Sciences | TGF-β and Physiological Root Resorption of Deciduous Teeth. pubmed:28035998 |
| BMC Veterinary Research | Lymphocytic, cytokine and transcriptomic profiles in peripheral blood of dogs with atopic dermatitis pubmed:27553600 |
| immunology letters | Recombinant Mip-PilE-FlaA dominant epitopes vaccine candidate against Legionella pneumophila. pubmed:28366526 |
| immunology letters | Gemcitabine treatment enhanced the anti-tumor effect of cytokine induced killer cells by depletion of CD4+CD25bri regulatory T cells. pubmed:27867030 |
| Journal of Cardiovascular Electrophysiology | Effect of Cardiac Resynchronization Therapy on Myocardial Fibrosis and Relevant Cytokines in a Canine Model With Experimental Heart Failure. pubmed:28127817 |
| Molecular Medicine Reports | The protective role of vitamin D3 in a murine model of asthma via the suppression of TGF-β/Smad signaling and activation of the Nrf2/HO-1 pathway. pubmed:27484042 |
| International Immunopharmacology | Amelioration of bleomycin-induced lung fibrosis in rats by valproic acid and butyrate: Role of nuclear factor kappa-B, proinflammatory cytokines and oxidative stress pubmed:27526269 |
| Cellular Physiology and Biochemistry | Renal Denervation Attenuates Multi-Organ Fibrosis and Improves Vascular Remodeling in Rats with Transverse Aortic Constriction Induced Cardiomyopathy pubmed:27889753 |
| Canadian Journal of Physiology and Pharmacology | The effect of midkine on growth factors and oxidative status in an experimental wound model in diabetic and healthy rats pubmed:28177680 |
| PLoS One. | Differential frequency of CD8+ T cell subsets in multiple sclerosis patients with various clinical patterns pubmed:27467597 |
| Therapeutics and Clinical Risk Management | Elevated blood plasma levels of epinephrine, norepinephrine, tyrosine hydroxylase, TGFβ1, and TNFα associated with high-altitude pulmonary edema in an Indian population. pubmed:27540296 |
| Journal of Cancer Research and Treatment | Effect of Indole-3-carbinol and/or Metformin on Female Patients with Ulcerative Colitis (Premalignant Condition): Role of Oxidative Stress, Apoptosis and Proinflammatory Cytokines jcrt:5 |
| Sci Rep | Follistatin like-1 aggravates silica-induced mouse lung injury PMC5428474 |
| Ren Fail. | Effect of concomitant administration of coenzyme Q10 with sitagliptin on experimentally induced diabetic nephropathy in rats. pubmed:27841100 |
| Basic Clin Pharmacol Toxicol. | Magnolol Attenuates Concanavalin A-induced Hepatic Fibrosis, Inhibits CD4+ T Helper 17 (Th17) Cell Differentiation and Suppresses Hepatic Stellate Cell Activation: Blockade of Smad3/Smad4 Signalling. pubmed:28032440 |
| Acta Vet Hung. | Imbalance of intestinal immune function in piglets infected by porcine circovirus type 2 during the fetal period. pubmed:28244338 |
| Gut Pathog. | Oral administration of Clostridium butyricum CGMCC0313‐1 reduces ovalbumin‐induced allergic airway inflammation in mice pubmed:28250847 |
| Environmental Toxicology and Pharmacology | Ameliorative potential of linagliptin and/or calcipotriol on bleomycin-induced lung fibrosis: In vivo and in vitro study pubmed:28192751 |
| PeerJ | Platelet-rich concentrate in serum free medium enhances osteogenic differentiation of bone marrow-derived human mesenchymal stromal cells pubmed:27651984 |
| Biomedical and Environmental Sciences | Crystalline Silica Promotes Rat Fibrocyte Differentiation in Vitro, and Fibrocytes Participate in Silicosis in Vivo pubmed:29081339 |
| Toxicology and Applied Pharmacology | Sildenafil protects against bile duct ligation induced hepaticfibrosis in rats: Potential role for silent information regulator 1 (SIRT1) pubmed:28974454 |
| Oral Diseases | Glucosamine oral administration as an adjunct to hyaluronic acid injection in treating temporomandibular joint osteoarthritis pubmed:28862770 |
| Biomedicine & Pharmacotherapy | Cytokine production in vitro and in rat model of colitis in response to Lactobacillus plantarum LS/07 pubmed:28830068 |
| Research in Veterinary Science | The effect of feed supplementation with effective microorganisms(EM) on pro- and anti-inflammatory cytokine concentrations in pigs pubmed:28549299 |
| Journal of Materials Chemistry B | Extracellular Matrix Powder from Cultured Cartilage-Like Tissue as Cell Carriers for Cartilage Repair DOI:10.1039/C7TB00640C |
| National Natural Scientific | Role of Gut-Derived Endotoxin on Type I Collagen Production in the Rat Pancreas after Chronic Alcohol Exposure pubmed:29121396 |
| Basic & Clinical Pharmacology & Toxicology | Magnolol Attenuates Concanavalin A-induced Hepatic Fibrosis, Inhibits CD4 + T Helper 17(Th17) Cell Differentiation and Suppresses Hepatic Stellate Cell Activation: Blockade of Smad3/Smad4 Signalling doi:10.1111 |
| Experiental And Therapeutic Medicine | Plasma proteins as potential targets of abnormal Savda syndrome in asthma patients treated with unique Uighur prescription pubmed:28672924 |
| Oncotarget. | Tumor-associated macrophages promote tumor metastasis via the TGF-β/SOX9 axis in non-small cell lung cancer pubmed:29245941 |
| International Journal of Chemical Studies | Studies on quality attributes of skimmed colostrum powder P-ISSN: 2349–8528 |
| Scientific RepoRts | Follistatin like-1 aggravates silicainduced mouse lung injury pubmed:28341862 |
| Evidence-Based Complementary and Alternative Medicine | Cardioprotection against Heart Failure by Shenfu Injection via TGF-β/Smads Signaling Pathway pubmed:28698735 |
| Molecular Medicine Reports | Pigment epithelium‑derived factor protects human glomerular mesangial cells from diabetes via NOXO1‑iNOS suppression 10.3892/mmr.2017.7563 |
| ARTIFICIAL CELLS NANOMEDICINE AND BIOTECHNOLOGY | Dexamethasone reduces serum level of IL-17 in Bleomycin-A5-induced rats model of pulmonary fibrosis pubmed:28608724 |
| Cell Physiol Biochem | Exendin-4 Induces Bone Marrow Stromal Cells Migration Through Bone Marrow-Derived Macrophages Polarization via PKA-STAT3 Signaling Pathway pubmed:29216639 |
| Chemico-biological Interactions | The promising effect of linagliptin and/or indole-3-carbinol on experimentally-induced polycystic ovarian syndrome. pubmed:28619389 |
| PLoS One | Protective effect of aplysin on liver tissue and the gut microbiota in alcohol-fed rats pubmed:28622357 |
| Evidence-based complementary and alternative medicine | Qiliqiangxin Enhances Cardiac Glucose Metabolism and Improves Diastolic Function in Spontaneously Hypertensive Rats pubmed:28706558 |
| Molecular and Cellular Neuroscience | TGF-β1 enhances phagocytic removal of neuron debris and neuronal survival by olfactory ensheathing cells via integrin/MFG-E8 signaling pathway 10.1016/j.mcn.2017.08.006 |
| Journal of Thoracic Oncology | Systemic and Tumor Th1 and Th2 Inflammatory Profile and Macrophages in Lung Cancer: Influence of Underlying Chronic Respiratory Disease. pubmed:27793775 |
| Journal of Controlled Release | Nose-to-brain delivery of insulin enhanced by a nanogel carrier Pubmed:29196041 |
| Journal of Cellular And Molecular Medicine | Lipopolysaccharide enhances TGF‐β1 signalling pathway and rat pancreatic fibrosis Pubmed:29424488 |
| International Journal of Biochemistry & Cell Biology | Quercetin ameliorates pulmonary fibrosis by inhibiting SphK1/S1P signaling Pubmed:29940125 |
| Physiology & Behavior | Linagliptin potentiates the effect of l-dopa on the behavioural, biochemical and immunohistochemical changes in experimentally-induced Parkinsonism: Role of toll … Pubmed:29410018 |
| Journal of Molecular Neuroscience | A Novel scFv Anti-Aβ Antibody Reduces Pathological Impairments in APP/PS1 Transgenic Mice via Modulation of Inflammatory Cytokines and Aβ-related Enzymes Pubmed:30062438 |
| Oncotarget | Nucleoside reverse transcriptase inhibitor-induced rat oocyte dysfunction and low fertility mediated by autophagy Pubmed:29423092 |
| Oncotarget | Hypoxia-inducible factor-1α activates transforming growth factor-β1/Smad signaling and increases collagen deposition in dermal fibroblasts Pubmed:29423039 |
| Communications Biology | Activated hepatic stellate cells promote epithelial-to-mesenchymal transition in hepatocellular carcinoma through transglutaminase 2-induced pseudohypoxia |
| Bulletin of Experimental Biology and Medicine | Expression of Hif-1α, Nf-κb, and Vegf Genes in the Liver and Blood Serum Levels of HIF-1α, Erythropoietin, VEGF, TGF-β, 8-Isoprostane, and Corticosterone in Wistar Rats with High and Low Resistance to Hypoxia. Corticosterone in … Pubmed: 30353332 |
| Phytomedicine | Mechanistic insights to the cardioprotective effect of Blueberry Nutraceutical Extract in Isoprenaline-Induced Cardiac Hypertrophy |
| Veterinary Immunology and Immunopathology | Evaluation of T regulatory lymphocytes and serum concentration of selected cytokines in dogs with perianal tumors |
| Experimental and Therapeutic Medicine | Rhynchophylline attenuates allergic bronchial asthma by inhibiting transforming growth factor‑β1‑mediated Smad and mitogen‑activated protein kinase signaling … |
| Biology of Reproduction | Recombinant adiponectin alleviates abortion in mice by regulating Th17/Treg imbalance via p38MAPK-STAT5 pathway Pubmed: 30496353 |
| International Journal of Peptide Research and Therapeutics | ANP/NPRA Inhibits Epithelial-Mesenchymal Transition of Airway by Targeting Smad3 in Asthma |
| Journal of Neuroinflammation | Anti-inflammatory and cognitive effects of interferon-β1a (IFNβ1a) in a rat model of Alzheimer's disease Pubmed: 30777084 |
| Biochimie | Periostin contributes to renal and cardiac dysfunction in rats with chronic kidney disease: reduction of PPARα Pubmed: 30890453 |
| Molecular Medicine Reports | Astaxanthin ameliorates renal interstitial fibrosis and peritubular capillary rarefaction in unilateral ureteral obstruction Pubmed: 30816496 |
| International Journal of Nanomedicine | Improving the anti-keloid outcomes through liposomes loading paclitaxel–cholesterol complexes Pubmed: 30863067 |
| Behavioural Brain Research | THE ROLE OF ANTI-INFLAMMATORY CYTOKINES IN MEMORY PROCESSING IN A HEALTHY BRAIN |
| International Journal of Ophthalmology | A novel xeno-free culture system for human retinal pigment epithelium cells Pubmed: 31024807 |
| Open Access Macedonian Journal of Medical Sciences | Low Degree Hyaluronic Acid Crosslinking Inducing the Release of TGF-Β1 in Conditioned Medium of Wharton's Jelly-Derived Stem Cells |
| 中国免疫学杂志 | TRAF-6 调控TGF-β1-Smad2/Smad3 信号通路在Graves 病免疫发病机制中的作用 |
| Food & Function | Network pharmacology oriented study reveals inflammatory state-dependent dietary supplement hepatotoxicity responses in normal and diseased rats Pubmed: 31140472 |
| Annals of clinical and laboratory science | CD19+ CD24hiCD38hi Regulatory B cells Involved in Hepatic Alveolar Hydatid Infection in Humans Pubmed: 31308033 |
| Life sciences | Pioglitazone attenuates kidney fibrosis via miR-21-5p modulation Pubmed: 31254585 |
| Acta Histochemica | Hyperoside protects against heart failure-induced liver fibrosis in rats Pubmed: 31353051 |
| Cardiology | Circulating Connective Tissue Growth Factor Is Associated with Diastolic Dysfunction in Patients with Diastolic Heart Failure Pubmed: 31466059 |
| Scientific Reports | Anti-inflammatory and antioxidant effects of muscarinic acetylcholine receptor (mAChR) activation in the rat hippocampus Pubmed: 31578381 |
| toxicology and applied pharmacology | miR-181b-5p inhibits endothelial-mesenchymal transition in monocrotaline-induced pulmonary arterial hypertension by targeting endocan and TGFBR1 Pubmed: 31734320 |
| Experimental Cell Research | CD4+ CD25+ Tregs as dependent factor in the course of bleomycin-induced pulmonary fibrosis in mice Pubmed: 31678213 |
| Prostaglandins & other Lipid Mediators | Lipoxin A4 inhibited the activation of Hepatic Stellate Cells-T6 cells by modulating profibrotic cytokines and NF-κB signaling pathway Pubmed: 31698141 |
| International Journal of Rheumatic Diseases | Effects of thalidomide on Th17, Treg cells and TGF‐β1/Smad3 pathway in a mouse model of systemic sclerosis Pubmed: 31840939 |
| Pigment Cell & Melanoma Research | Altered expression of nuclear factor of activated T cells, Forkhead Box P3 and immune suppressive genes in regulatory T cells of generalized vitiligo patients Pubmed: 31917889 |
| Cell Communication and Signaling | Rapamycin promotes endothelial–mesenchymal transition during stress-induced premature senescence through the activation of autophagy Pubmed: 32164764 |
| Biomed Pharmacother | Soufeng Yuchuan decoction mitigates the ovalbumin-induced lung damage in a rat model of asthma Pubmed: 32036215 |
| Biochemical and Biophysical Research Communications | Isorhynchophylline exerts anti-asthma effects in mice by inhibiting the proliferation of airway smooth muscle cells: The involvement of miR-200a-mediated FOXC1/NF … Pubmed: 31733831 |
| INTERNATIONAL JOURNAL OF MOLECULAR SCIENCES | Vitamin D Attenuates Loss of Endothelial Biomarker Expression in Cardio-Endothelial Cells Pubmed: 32235811 |
| Journal of Oral Biology and Craniofacial Research | Levels of TGF-β1 in peri-miniscrew implant crevicular fluid Pubmed: 32211284 |
| Acta Histochem | Paeoniflorin accelerates foot wound healing in diabetic rats though activating the Nrf2 pathway Pubmed: 33166863 |
| EUROPEAN JOURNAL OF PHARMACOLOGY | The anti-asthmatic potential of flavonol kaempferol in an experimental model of allergic airway inflammation Pubmed: 33122672 |
| Journal of Cosmetic Dermatology | Examination of androgenetic alopecia with serum biomarkers Pubmed: 32969583 |
| MOLECULAR AND CELLULAR BIOCHEMISTRY | Soluble recombinant human thrombomodulin suppresses inflammation-induced gastrointestinal tumor growth in a murine peritonitis model Pubmed: 32767229 |
| CANADIAN JOURNAL OF PHYSIOLOGY AND PHARMACOLOGY | Hepatoprotective effect of Linagliptin against liver fibrosis induced by carbon tetrachloride in mice Pubmed: 32726558 |
| EXPERIMENTAL DERMATOLOGY | Decreased suppression of CD8+ and CD4+ T cells by peripheral Regulatory T cells in Generalized Vitiligo due to reduced NFATC1 and FOXP3 proteins Pubmed: 32682346 |
| Scientific Reports | Erlotinib can halt adenine induced nephrotoxicity in mice through modulating ERK1/2, STAT3, p53 and apoptotic pathways Pubmed: 32661331 |
| international journal of biological macromolecules | Chlorella vulgaris α-L-arabino-α-L-rhamno-α, β-D-galactan structure and mechanisms of its anti-inflammatory and anti-remodelling effects Pubmed: 32565301 |
| Exp Cell Res | Exosomal miR-532–5p from bone marrow mesenchymal stem cells reduce intervertebral disc degeneration by targeting RASSF5 Pubmed: 32464126 |
| JOURNAL OF IMMUNOLOGY RESEARCH | The Sufficient Immunoregulatory Effect of Autologous Bone Marrow-Derived Mesenchymal Stem Cell Transplantation on Regulatory T Cells in Patients with … Pubmed: 32411794 |
| Frontiers in Pharmacology | M10, a Myricetin-3-ObD-Lactose Sodium Salt, Prevents Ulcerative Colitis Through Inhibiting Necroptosis in Mice Pubmed: 33041798 |
| Food & Function | Nicotinamide riboside alleviates alcohol-induced depression-like behaviours in C57BL/6J mice by altering the intestinal microbiota associated with microglial … |
| Effect of metformin and indole-3-carbinol on a rat model of Parkinson's disease induced by 6-hydroxydopamine | |
| Research square | Vitamin D Status in Dupuytren's Disease: Association with Clinical Status and Vitamin D Receptor Expression |
| Phytomedicine | Menthacarin attenuates experimental colitis |
| Immunomodulatory effects of sCD83 via induction of TGF-β1 and IDO: an in vitro and rat orthotopic liver transplantation study | |
| BMC Complement Med Ther | Suppression of autophagy through JAK2/STAT3 contributes to the therapeutic action of rhynchophylline on asthma 33413331 |
| Life Sci | Celecoxib ameliorates liver cirrhosis via reducing inflammation and oxidative stress along spleen-liver axis in rats 33577848 |
| CLINICAL SCIENCE | Berberine accelerated wound healing by restoring TrxR1/JNK in diabetes 33491733 |
| Bioact Mater | New design to remove leukocytes from platelet-rich plasma (PRP) based on cell dimension rather than density 33842739 |
| Acta Biomater | Highly interconnected inverse opal extracellular matrix scaffolds enhance stem cell therapy in limb ischemia 33878473 |
| Mol Cell Biochem | Human umbilical cord-derived mesenchymal stem cells and their chondroprogenitor derivatives reduced pain and inflammation signaling and promote regeneration in?¡ 33864569 |
| Cell Death & Disease | Sodium/glucose cotransporter 1-dependent metabolic alterations induce tamoxifen resistance in breast cancer by promoting macrophage M2 polarization 34006822 |
| PLoS One | Beneficial impact of cathelicidin on hypersensitivity pneumonitis treatment¡ªIn vivo studies 33999928 |
| Vascular pharmacology | Nectin-4 promotes lymphangiogenesis and lymphatic metastasis in breast cancer by regulating CXCR4-LYVE1 axis 33945869 |
| Equine Vet J | Limited added value of negative pressure wound therapy compared to calcium alginate dressings for second intention healing in a non©\contaminated and?¡ 34115409 |
| Stem Cells International | The Paracrine Effect of Adipose-Derived Stem Cells Orchestrates Competition between Different Damaged Dermal Fibroblasts to Repair UVB-Induced Skin?¡ 33381190 |
| Journal of Pharmacy and Pharmacology | Pharmacodynamic evaluation of dihydroxyflavone derivate chrysin in a guinea pig model of allergic asthma 33793800 |
| Bull. Egypt. Soc. Physiol. Sci. | Flaxseed Oil Supplementation Afford Comparable Therapeutic effect to Metformin in Bleomycin Induced Pulmonary Fibrosis Rat model |
| У¿¯ | Role of Angiotensin II and Renal Nerves on TGF-b/SmadPathway in Diabetic Nephropathy Rat Model |
| Bioactive Materials | Calcium phosphate-based materials regulate osteoclast-mediated osseointegration |
| Mediators of Inflammation | Sparstolonin B Exerts Therapeutic Effects on Collagen-Induced Arthritis by Inhibiting the NLRP3 Inflammasome and Reducing the Activity of ¦Á1, 3 ¡ |
| Manuscript title Microparticles Containing MiR-625-5p In Coronary Artery Reduce Myocardial Fibrosis After Myocardial Infarction | |
| Andrology | X‐ray micro‐computed tomography in the assessment of penile cavernous fibrosis in a rabbit castration model 34236146 |
| Aging | Yiqi Jiemin decoction alleviates allergic rhinitis in a guinea pig model by suppressing inflammation, restoring Th1/Th2 balance, and improving cellular … 34315133 |
| Tissue Eng Regen Med | Effect of Leukocyte-Platelet Rich Fibrin (L-PRF) on Tissue Regeneration and Proliferation of Human Gingival Fibroblast Cells Cultured Using a Modified Method 34339025 |
| Am J Transl Res | Wuling San and Xiao Chaihu Decoction affect airway inflammatory response and airway smooth muscle cell proliferation in mice with allergic asthma via miR … 34786062 |
| Biomacromolecules | In Situ Forming Cellulose Nanofibril-Reinforced Hyaluronic Acid Hydrogel for Cartilage Regeneration 34723499 |
| Brain Sci | Neuroprotective Effect of Clobenpropit against Lipopolysaccharide-Induced Cognitive Deficits via Attenuating Neuroinflammation and Enhancing Mitochondrial … 34942919 |
| Biomedicines | Exploring Epithelial–Mesenchymal Transition Signals in Endometriosis Diagnosis and In Vitro Fertilization Outcomes 34829910 |
| J Inflamm Res | Clenbuterol, a Selective β2-Adrenergic Receptor Agonist, Inhibits or Limits Post-Stroke Pneumonia, but Increases Infarct Volume in MCAO Mice Pubmed:35058704 |
| Cancer Commun (Lond) | Anti‐PD‐L1/TGF‐βR fusion protein (SHR‐1701) overcomes disrupted lymphocyte recovery‐induced resistance to PD‐1/PD‐L1 inhibitors in lung cancer Pubmed:34981670 |
| Polymers (Basel) | 3D Printed Scaffold Based on Type I Collagen/PLGA_TGF-β1 Nanoparticles Mimicking the Growth Factor Footprint of Human Bone Tissue Pubmed:35267680 |
| Biomed Pharmacother | Jiangu granule ameliorated OVX rats bone loss by modulating gut microbiota-SCFAs-Treg/Th17 axis Pubmed:35453007 |
| Biomed Pharmacother | Huangbai liniment and berberine promoted wound healing in high-fat diet/Streptozotocin-induced diabetic rats Pubmed:35430394 |
| Antioxidants | Bio-Evaluation of the Wound Healing Activity of Artemisia judaica L. as Part of the Plant's Use in Traditional Medicine; Phytochemical, Antioxidant, Anti-Inflammatory … Pubmed:35204215 |
| Frontiers in Molecular Neuroscience | Red Nucleus Interleukin-6 Evokes Tactile Allodynia in Male Rats Through Modulating Spinal Pro-inflammatory and Anti-inflammatory Cytokines Pubmed:35465093 |
| Vaccines | Age-Dependent Dynamics of Maternally Derived Antibodies (MDAs) and Understanding MDA-Mediated Immune Tolerance in Foot-and-Mouth Disease-Vaccinated … Pubmed:35632433 |
| Biomaterials Advances | Human adipose-derived stem cell-loaded small intestinal submucosa as a bioactive wound dressing for the treatment of diabetic wounds in rats |